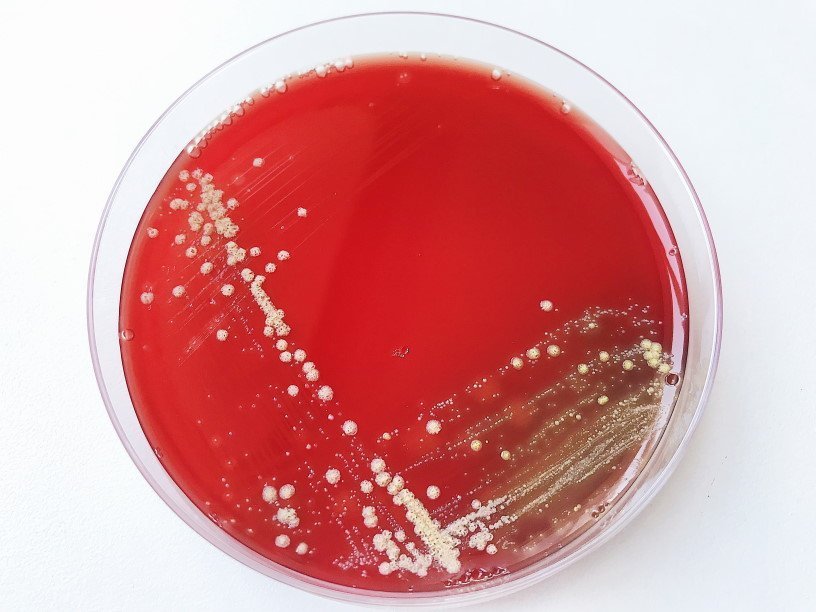

Екатерина Беленко: Промикробы: Кровь и пептон
Я уже рассказывала про кровяной агар, расхваливала эту незаменимую в медицинской микробиологии питательную среду. Кроме крови, в состав этой питательной среды (как и в состав многих других сред) входит пептон. Пептон — это препарат, получаемый из молока и мяса животных под действием ферментов. Другими словами, вкусный и питательный корм для бактерий. Одно из множества достоинств кровяного агара — возможность лицезреть гемолитическую активность наших маленьких подопечных.
⠀
Гемолиз — это разрушение оболочки эритроцитов крови, в результате которого гемоглобин выходит из клетки. Это очень широкое понятие, выходящее далеко за рамки микробиологии. Различают физиологический и патологический гемолиз. Физиологический — это необходимый завершающий этап жизненного цикла эритроцитов, они тоже простые смертные. Патологический гемолиз наблюдается при гемолитической анемии, под влиянием ядов, при переливании несовместимой крови и при резусном конфликте, при аллергиях и при воздействии холода.
⠀
Патологический гемолиз может быть абсолютно разным, например:
• осмотический (когда слишком много воды поступает в клетки и они тупо лопаются);
• механический (например, при сильном встряхивании пробирки с кровью);
• температурный (бывает холодовой и тепловой);
• химический.
⠀
Вот он-то нас и интересует. Химический гемолиз возникает при разрушении мембран эритроцитов различными химическими веществами. Это могут быть кислоты или щёлочи, яды змей или насекомых, нитраты или бензол, вирусы или токсины микробов. И вот только здесь мы приблизились к микробиологии.
⠀
Не все бактерии это умеют, но некоторые выделяют гемолизины — вещества, разрушающие эритроциты. На кровяном агаре колонии таких микробов окружают зоны просветления. Сам факт образования гемолизинов, а также размеры зон гемолиза и их цвет — это важные диагностические признаки. По ним можно определить, кого это мы такого вырастили. Для адекватного определения гемолитической активности следует просматривать чашки с посевами против источника света.
⠀
Активность гемолизинов бывает двух типов — полная и неполная. Если разрушение эритроцитов было неполным, то сохраняется клеточная строма. Просветление среды вокруг таких колоний обычно незначительное, позднее среда вокруг колоний может приобретать зеленоватую окраску. Тогда это альфа-гемолиз. Подобный рост характерен для пневмококка, а также для группы так называемых зеленящих стрептококков. Гораздо больше группа бактерий, вызывающих полное разрушение эритроцитов, или бета-гемолиз. Их колонии окружены прозрачными зонами различного размера. Попробуйте сами определить тип гемолиза на фотографии, почувствуйте себя самым настоящим микробиологом, изучающим посев мокроты.